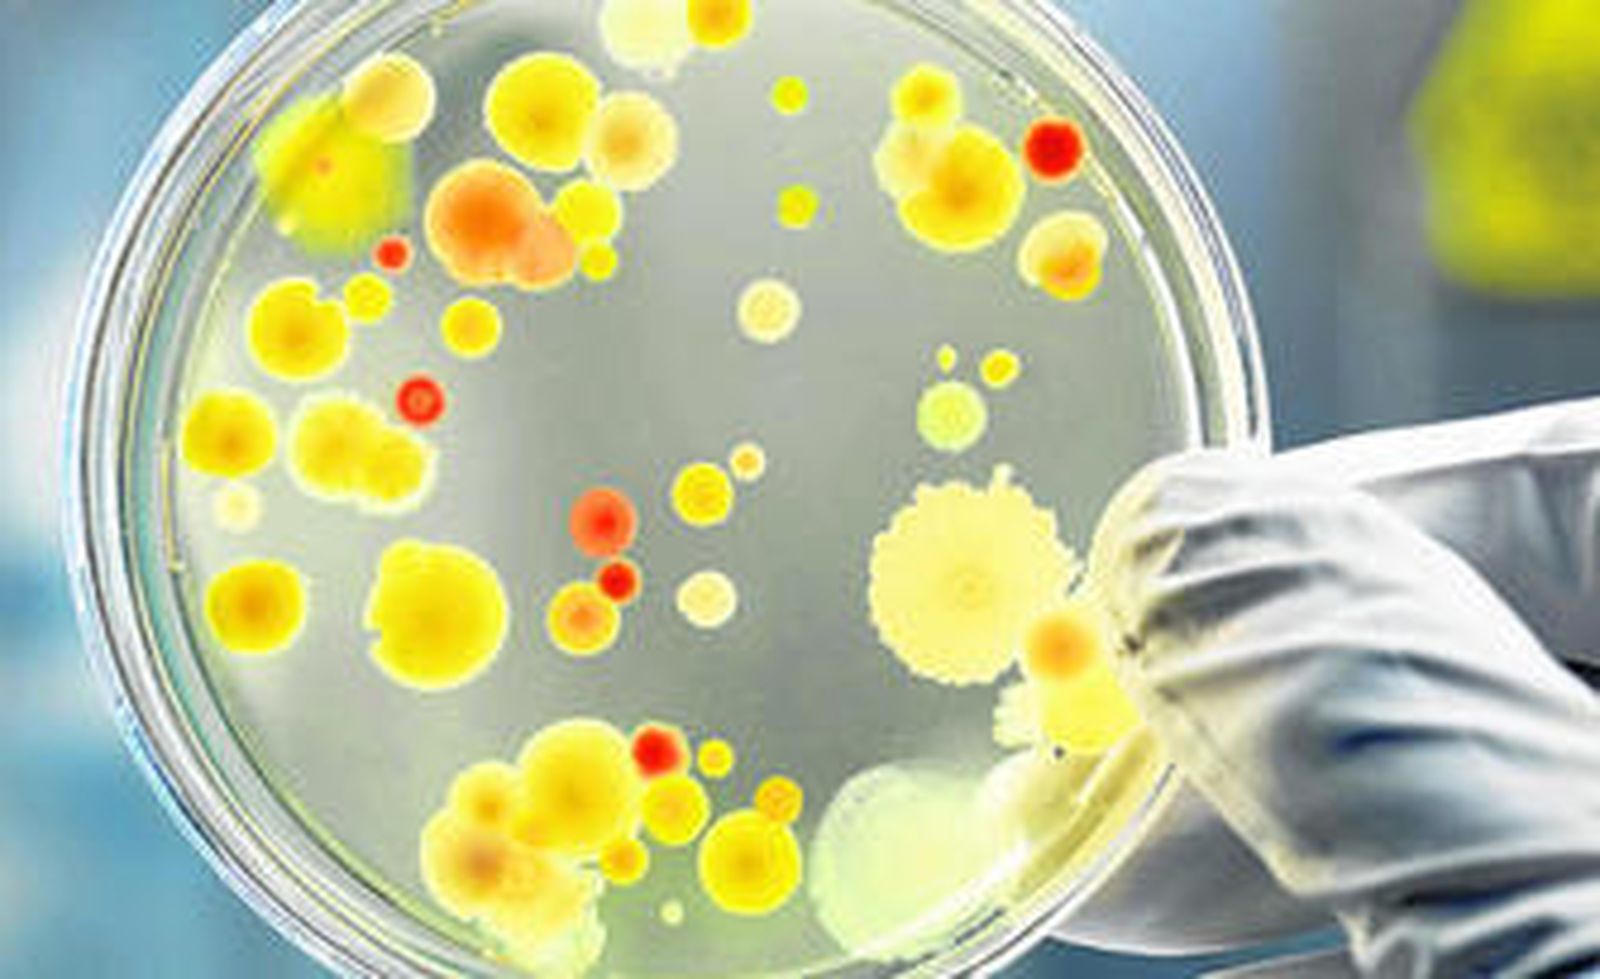

Fin al milagro antibiótico
El abuso de los antimicrobianos y la escasa llegada de nuevas moléculas favorecen la aparición de cepas capaces de ganar la batalla

Los antibióticos han salvado millones de vidas desde el importante hallazgo de la penicilina por Alexander Fleming en 1928. Sin embargo, lo que se conoce como la era del milagro de los antimicrobianos puede estar llegando a su fin debido al abuso de estos fármacos y a la reducción del ritmo de investigación de nuevas moléculas capaces de hacer frente a las cepas resistentes.
Si bien es cierto que la capacidad de adaptación de las bacterias no es un problema reciente, el presidente de la Sociedad Española de Enfermedades Infecciosas y Microbiología Clínica (Seimc), Rafael Cantón, alerta sobre un cambio de paradigma: "La resistencia es un simple mecanismo darwiniano de selección, la cuestión es que antes contábamos con la seguridad de que en poco tiempo aparecería una nueva molécula capaz de superarla, ahora no es así".
La Comisión Europea calcula que 25.000 personas mueren cada año en este continente debido a que sus organismos son incapaces de superar la resistencia creada por la bacteria a todos los fármacos existentes. Esta pérdida en vidas se refleja también en un aumento del gasto público, estimado en 1.500 millones de euros anuales, unas cifras que siguen creciendo pese a los intentos por parte de las administraciones de poner freno al problema.
Según el informe Antimicrobial resistance: global report on surveillance (Resistencia a los antimicrobianos: informe mundial sobre la vigilancia), la capacidad evolutiva es propia de muchos agentes infecciosos distintos, pero el problema se concentra en siete patógenos responsables de infecciones comunes graves, como la septicemia, la diarrea, la neumonía, las infecciones urinarias o la gonorrea.
Desde que, según Cantón, la comunidad científica advirtiera sobre la posibilidad de quedarnos sin antibióticos y la Organización Mundial de Salud (OMS) lo describiera en 2011 como una "grave amenaza para la salud pública en todo el mundo", los Gobiernos se han puesto manos a la obra. En Europa, la Oficina Regional de la OMS ha impulsado la creación de la Red de Vigilancia de la Resistencia de los Antimicrobianos en Asia Central y Europa Oriental (Caesar) con el objetivo de poner en común las políticas nacionales y en 2011 elaboró el Plan de Acción contra la Resistencia Bacteriana en búsqueda del compromiso de los Estados miembros y de todas las partes implicadas: médicos, trabajadores sanitarios, farmacéuticos, veterinarios y población en general.
En España, tal y como afirma el presidente de Seimc: "Se están haciendo los deberes", pero el punto de partida implica un mayor esfuerzo. Los estudios de la Seimc estiman que el consumo de antibióticos en España está por encima de la media. Unos datos que van en consonancia con la mayor tasa de automedicación de nuestro país respecto a otros países de la Unión (España ocupa el tercer puesto tras Lituania y Rumania).
Las últimas cifras muestran que el 85% del consumo de antibióticos es extrahospitalario y el 30% se realiza sin prescripción médica. "La responsabilidad es compartida, los profesionales sanitarios abusan de la prescripción, pero, en numerosas ocasiones, el paciente lo demanda o lo consume sin indicación porque utiliza los fármacos que le sobraron de otro tratamiento", explica Cantón.
Con el fin de cumplir con el Plan contra la Resistencia Bacteriana Europeo, España ha puesto en marcha el Programa optimización de uso de antimicrobianos (PROA) que tiene como objetivo mejorar los resultados clínicos de los pacientes con infecciones, minimizar los efectos adversos asociados a la utilización de antimicrobianos y garantizar la utilización de tratamientos coste-eficaces. A este programa se le unen otras medidas aisladas, como la formación de profesionales médicos en la prescripción adecuada de antimicrobianos, realizada recientemente por la Consejería de Salud de la Junta de Andalucía.
Los expertos esperan que la suma de todas estas iniciativas logre contener el avance de la resistencia bacteriana y se evite el panorama desolador que vislumbraba en 2011 el Subdirector General de la OMS para Seguridad Sanitaria, Keiji Fukuda: "En ausencia de medidas urgentes y coordinadas por parte de muchos interesados directos, el mundo está abocado a una era posantibióticos en la que infecciones comunes y lesiones menores que han sido tratables durante decenios volverán a ser potencialmente mortales".
También te puede interesar
Lo último








